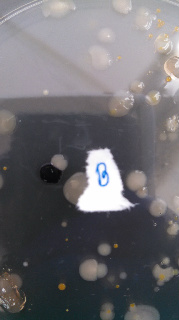
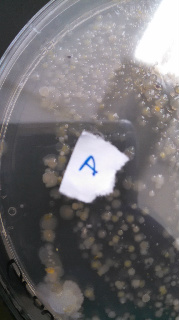

Uploads by Sophia C Zbesko
From OpenWetWare
Jump to navigationJump to search
This special page shows all uploaded files.
| Date | Name | Thumbnail | Size | Description |
|---|---|---|---|---|
| 02:53, 18 March 2015 | Gelthing.jpg (file) | 28 KB | ||
| 01:05, 5 March 2015 | Imagegel.jpeg (file) | 200 KB | ||
| 01:01, 5 March 2015 | GelImagine.jpeg (file) | 186 KB | ||
| 02:26, 19 February 2015 | Foodweb0.jpg (file) | 85 KB | ||
| 02:26, 19 February 2015 | Centipeed.jpg (file) | 13 KB | ||
| 04:16, 16 February 2015 | InvertebrateChart1.jpg (file) | 60 KB | ||
| 04:03, 16 February 2015 | Mite.jpg (file) | 17 KB | ||
| 04:03, 16 February 2015 | Beetle.jpg (file) | 23 KB | ||
| 03:58, 16 February 2015 | Mite.jpeg (file) | 70 KB | ||
| 03:57, 16 February 2015 | InvertebrateChart.jpg (file) | 52 KB | ||
| 01:32, 10 February 2015 | 800px-IMG Plant5.JPG (file) | 78 KB | ||
| 01:32, 10 February 2015 | 800px-IMG TransPlant3.JPG (file) | 123 KB | ||
| 01:31, 10 February 2015 | 800px-IMG TransPlant5.JPG (file) | 205 KB | ||
| 01:31, 10 February 2015 | 800px-IMG TransPlant4.JPG (file) | 193 KB | ||
| 01:31, 10 February 2015 | 800px-IMG Plant4.JPG (file) | 70 KB | ||
| 01:31, 10 February 2015 | 800px-IMG Plant3.JPG (file) | 71 KB | ||
| 01:30, 10 February 2015 | 600px-IMG TransPlant2.JPG (file) | 178 KB | ||
| 01:29, 10 February 2015 | 800px-IMG Plant2.JPG (file) | 77 KB | ||
| 01:29, 10 February 2015 | 800px-IMG TransPlant1.JPG (file) | 208 KB | ||
| 01:27, 10 February 2015 | 800px-IMG Plant1.JPG (file) | 52 KB | ||
| 01:25, 10 February 2015 | BerleseFunnelCollection.JPG (file) | 70 KB | ||
| 01:14, 10 February 2015 | Plantchart.jpg (file) | 126 KB | ||
| 04:13, 5 February 2015 | StainD.jpg (file) | 30 KB | ||
| 04:13, 5 February 2015 | StainC.jpg (file) | 29 KB | ||
| 04:13, 5 February 2015 | StainB.jpg (file) | 27 KB | ||
| 04:13, 5 February 2015 | StainA.jpg (file) | 26 KB | ||
| 04:13, 5 February 2015 | SampleD.jpg (file) | ![]() |
40 KB | |
| 04:13, 5 February 2015 | SampleC.jpg (file) | 54 KB | ||
| 04:12, 5 February 2015 | SampleB.jpg (file) | ![]() |
22 KB | |
| 04:12, 5 February 2015 | SampleA.jpg (file) | ![]() |
28 KB | |
| 03:48, 5 February 2015 | B stain.jpg (file) | 1.06 MB | ||
| 03:40, 5 February 2015 | Table20.jpg (file) | 71 KB | ||
| 19:10, 28 January 2015 | Colpidium.jpg (file) | 41 KB | ||
| 19:09, 28 January 2015 | Chlamydomas.jpg (file) | 39 KB | ||
| 19:04, 28 January 2015 | Eudorina.jpg (file) | 43 KB | ||
| 04:19, 26 January 2015 | Day1.jpg (file) | 155 KB | ||
| 04:18, 26 January 2015 | ABC.jpeg (file) | 54 KB | ||
| 04:01, 26 January 2015 | Top Map.jpeg (file) | 54 KB | A topographical aerial map of transect. | |
| 03:32, 26 January 2015 | TopographicalMap.jpeg (file) | 54 KB | A topographical aerial map of transect. |